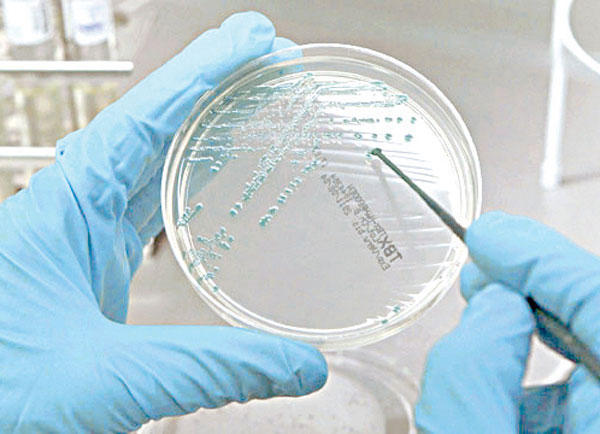

الصحة مجدداً: لا إصابات ببكتيريا إي كولاي في الكويت
أكدت وزارة الصحة أنها تتابع تطورات بكتيريا "إي - كولاي" التي انتشرت في عدد من الدول الأوروبية خلال شهر مايو الماضي عن كثب، مجددة تصريحها بشأن عدم تلقي الوزارة أي بلاغات عن حدوث مثل هذه الحالات في الكويت.
وقالت مديرة إدارة الصحة العامة د. فاطمة السعيدي إن الإدارة تتابع، بصورة مستمرة، البيانات والنشرات الوبائية والإرشادات التي تصدرها منظمة الصحة العالمية في هذا الشأن، لافتة إلى أن تقارير المنظمة أشارت إلى أن العدوى بالسلالة الحالية من بكتيريا "إي كولاي" (المعروفة بسلالة 0104:H4) التي بدأ ظهورها في بداية شهر مايو الماضية بألمانيا وانتشرت في بعض الدول الأوروبية بعد ذلك لم تحدث بشكل وبائي من قبل.وأوضحت السعيدي أن العدوى حدثت بصورة متفرقة وفردية ويصاحب هذه العدوى آلام في البطن وإسهال يكون مصحوبا بالدم في بعض الأحيان، وقد يحدث قيء أو ارتفاع طفيف بالحرارة في بعض الحالات، مضيفة أنه بالرغم من وجود هذه البكتيريا بشكل طبيعي وغير ضار بأمعاء الإنسان والحيوان فإن بعض سلالاتها قد تؤدي إلى حدوث اسهال مصحوب بدم بصورة وبائية في بعض الأحيان (مثل السلالة الحالية).سلامة الأغذيةوأضافت السعيدي أن الوزارة بادرت بطلب دعوة لجنة سلامة الأغذية بصورة عاجلة لدراسة تقارير منظمة الصحة العالمية، حيث رأت اللجنة حظر استيراد الخضراوات الطازجة من ألمانيا وإسبانيا وبقاء اللجنة في حالة اجتماع مستمر لدراسة المستجدات في هذا الشأن أولاً بأول، وهو ما ثمنته إدارة الصحة العامة.وأشارت إلى أن وزارة الصحة، ممثلة بإدارة الصحة العامة وبالتعاون والتنسيق مع الوزارات والهيئات والادارات ذات الصلة، تقوم بتشديد الرقابة الصحية على سلامة الأغذية، وعلى متداولي الأغذية والبدء بالرقابة الصحية على القادمين من البلدان التي ينتشر فيها المرض، وترصد حالات الإسهال والتعميم على الأطباء بالمستشفيات والمؤسسات الطبية الحكومية والأهلية بإجراءات الرصد والإبلاغ والتعامل مع الحالات المشتبه في إصابتها بالعدوى. وأوضحت أن الغالبية العظمى من حالات العدوى ببكتيريا "إي كولاي" تشفى تماما، وبنسبة لا تقل عن 90 في المئة إذا بادر المريض بمراجعة الطبيب فور شعوره بالأعراض مثل الإسهال المصحوب بالدم في بعض الأحيان، وآلام بالبطن وفي بعض الحالات يحدث قيء وارتفاع في درجة الحرارة.لا إصاباتوطمأنت مديرة إدارة الصحة العامة المواطنين والمقيمين إلى عدم تلقي الوزارة إلى أي بلاغات عن حدوث مثل هذه الحالات بدولة الكويت، ودعت المسافرين إلى ألمانيا والدول الأوروبية التي أعلنت منظمة الصحة العالمية WHO انتشار المرض بها إلى الالتزام بالتعليمات وبالإرشادات التي تصدرها السلطات الصحية بتلك البلاد.كما حذرت من تناول الخضراوات والفواكه الطازجة في تلك الدول، مع ضرورة مراجعة الطبيب في حالة حدوث أي أعراض وعدم قيام المريض من تلقاء نفسه بتناول المضادات الحيوية دون مراجعة الطبيب، لافتة في الوقت ذاته إلى أن منظمة الصحة العالمية لم توص بأي قيود على حركة السفر بشأن ألمانيا وتلك الدول.واختتمت د. فاطمة السعيدي تصريحها بأن وزارة الصحة ممثلة بإدارة الصحة العامة تتابع المستجدات العلمية أولاً بأول مع منظمة الصحة العالمية، وأنها ملتزمة بكل التوصيات والإرشادات التي تصدرها المنظمة، ولن تتوانى عن اتخاذ أية إجراءات احترازية إضافية قد تراها ضرورية للوقاية من العدوى بهذا المرض والمحافظة على الأمن الصحي للبلاد وصحة المواطنين والمقيمين.شفافيةوشددت على أن "الصحة" تحرص على انتهاج أسلوب الشفافية الكاملة للتعامل مع المجتمع والرأي العام من خلال وسائل الإعلام، والتي هناك ثقة بشأنها في ما يتعلق بحرصها على الرجوع إلى المصادر الرسمية للحصول على المعلومات الدقيقة والصحيحة حول الإجراءات الاحترازية التي تقوم بها الوزارة.